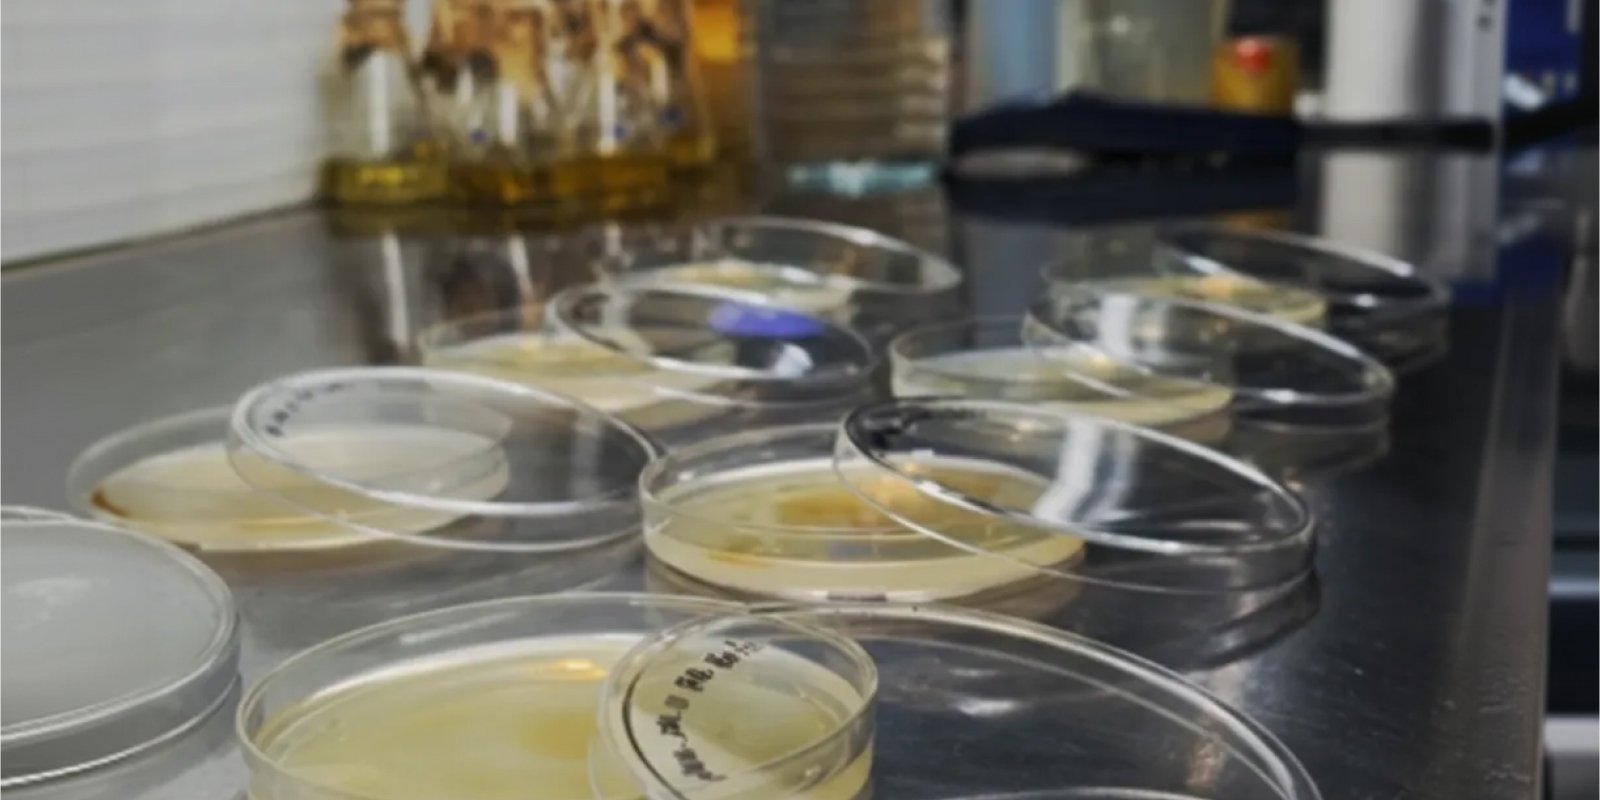

State-of-the-Art Research & Production Facilities
IFFCO-Nanoventions R&D Complex
Analytical Lab
IFFCO NANOVENTIONS Private Limited operates an advanced Analytical Lab dedicated to research and development. The lab is equipped with cutting-edge instrumentation for detailed analysis and characterization of nanomaterials and agricultural formulations. This facility plays a crucial role in ensuring the quality and efficacy of IFFCO’s innovative products.
At the lab, scientists conduct comprehensive tests to evaluate the physical, chemical, and biological properties of nanomaterials and their applications in agriculture. This includes studies on particle size, morphology, composition, and stability. The analytical findings contribute significantly to product optimization and formulation improvement.
The Analytical Lab at IFFCO NANOVENTIONS Private Limited is committed to maintaining high standards of quality control and innovation. By leveraging state-of-the-art technologies and expertise, the lab supports the development of sustainable and effective solutions for modern agriculture.
Instrumentation Lab
The Instrumentation Lab is a crucial facility dedicated to ensuring precise measurements and quality control in nanotechnology applications. Equipped with advanced instrumentation, this lab plays a pivotal role in research and development activities.
By maintaining stringent quality standards and leveraging cutting-edge technology, skilled technicians and scientists significantly contribute to the advancement of nanotechnology, fostering innovation and enhancing product performance. The lab boasts a comprehensive suite of chromatographic and spectrometric instruments, including High-Performance Liquid Chromatography (HPLC), Inductively Coupled Plasma Optical Emission Spectroscopy (ICP-OES), and Gas Chromatography-Mass Spectrometry (GC-MS). These technologies enable precise quantification of a diverse range of compounds and analyses materials at the nanoscale.
To ensure thorough examination of physical parameters, the lab is also equipped with instruments such as the BET surface analyzer, Optical tensiometer, and Simultaneous thermal analyzer, providing detailed insights into product characteristics. The efficiency and efficacy of products at the molecular level are rigorously tested using PCR systems, Gel documentation units, and Nano spectrophotometers. Furthermore, an innovative range of microscopes, including the inverted microscope, allows for effortless analysis of minute particles, ensuring comprehensive and accurate results. The lab’s capabilities extend to characterizing nanoparticles, assessing their properties, and optimizing production processes for various applications.
Bio Safety Lab
The Lab is a premier facility dedicated to research and development in bio-safety and molecular biology. Equipped with the latest technology, the lab focuses on innovating advanced biosafety products and solutions for diverse applications. Its research spans biotechnology, nanotechnology, and bio-engineering, aiming to enhance safety standards in healthcare, agriculture, and environmental sectors.
The lab’s primary goal is to develop novel biosafety solutions that meet global standards, ensuring safe handling of biological materials and mitigating biohazard risks. By leveraging interdisciplinary expertise, the facility explores innovative approaches to address emerging biosecurity challenges. The Bio Safety Lab plays a pivotal role in driving sustainable innovation and promoting biosecurity best practices for a safer and healthier future.
Synthesis Lab
The Synthesis Lab is a leading-edge facility focused on developing advanced nanotechnology-based solutions. This lab serves as a hub for innovation, specializing in the synthesis and characterization of nanomaterials for diverse applications. Equipped with top-tier equipment and staffed with highly skilled scientists and engineers, the lab conducts research to create novel materials with enhanced properties.
The primary objective of the Synthesis Lab is to harness the potential of nanotechnology to address various challenges across industries such as agriculture, healthcare, and environmental sustainability. By leveraging nanomaterials, the lab aims to develop products that improve efficiency, reduce environmental impact, and enhance performance in different sectors. Through a combination of expertise, infrastructure, and a commitment to innovation, the Synthesis Lab plays a pivotal role in driving technological advancements and creating impactful solutions for global challenges.
Bio Efficacy Chamber/ Environmental Chamber
At IFFCO NANOVENTIONS PRIVATE LIMITED, the bio efficacy chamber, also known as an environmental chamber, plays a crucial role in advancing agricultural technologies. This chamber provides a controlled environment essential for testing and optimizing the efficacy of various agricultural products, such as pesticides, fertilizers, and bio-stimulants.
The chamber simulates different environmental conditions, including temperature, humidity, and light, to mimic real-world scenarios where these products would be applied. This controlled setup allows researchers to accurately assess how these products perform under varying conditions, ensuring their effectiveness before they are introduced to the market.
By leveraging the bio efficacy chamber, IFFCO NANOVENTIONS PRIVATE LIMITED is committed to delivering innovative and reliable solutions that enhance agricultural productivity while minimizing environmental impact. This facility underscores their dedication to research and development aimed at supporting sustainable agriculture.
Innovation Upscaling Facility
The Lab is a premier facility dedicated to research and development in bio-safety and molecular biology. Equipped with the latest technology, the lab focuses on innovating advanced biosafety products and solutions for diverse applications. Its research spans biotechnology, nanotechnology, and bio-engineering, aiming to enhance safety standards in healthcare, agriculture, and environmental sectors.
The lab’s primary goal is to develop novel biosafety solutions that meet global standards, ensuring safe handling of biological materials and mitigating biohazard risks. By leveraging interdisciplinary expertise, the facility explores innovative approaches to address emerging biosecurity challenges. The Bio Safety Lab plays a pivotal role in driving sustainable innovation and promoting biosecurity best practices for a safer and healthier future.
Production Facility
IFFCO NANOVENTIONS PRIVATE LIMITED operates a fully automated production facility focused on nanotechnological formulation. The facility, situated in India, leverages advanced manufacturing processes to produce innovative nanomaterials and nanoproducts for various sectors, including agriculture, healthcare, and renewable energy. Equipped with leading-edge infrastructure and adhering to stringent quality standards, the facility is designed to cater to the growing demand for sustainable and high-performance nanotechnology solutions. At IFFCO NANOVENTIONS, the production process is characterized by precision and efficiency, ensuring consistent and reliable output. The facility’s research and development team collaborates closely with experts in nanoscience to continuously enhance product offerings and explore new applications. Through this facility, IFFCO NANOVENTIONS is contributing to the advancement of nanotechnology in India and globally, aiming to address pressing challenges across industries with innovative nano-based solutions.
R&D Farm
The R&D Farm serves as a pioneering hub for cutting-edge research and development in nanotechnology. This facility embodies innovation in agricultural solutions, leveraging nanoscience to enhance productivity and sustainability in farming. By integrating nanotechnology into agriculture, IFFCO Nanoventions aims to revolutionize crop protection, nutrient delivery, and soil management.
The R&D Farm facilitates rigorous experimentation, testing, and development of nanotech-driven products tailored to meet the challenges faced by farmers. It fosters collaboration between scientists, agronomists, and industry experts to create practical solutions that optimize resource efficiency and minimize environmental impact. The innovative spirit at IFFCO Nanoventions’ R&D Farm reflects a commitment to harnessing technology for the betterment of agriculture, ensuring that farmers can access advanced tools to achieve higher yields and improved livelihoods.